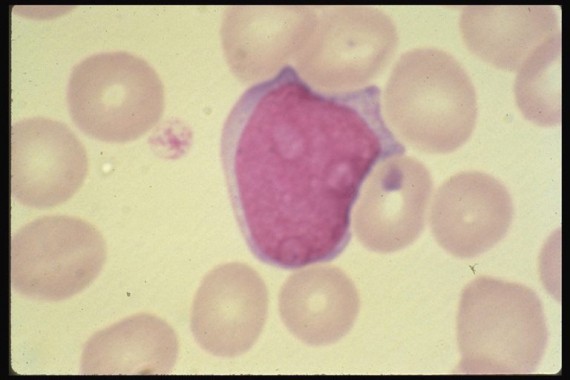
Myeloblast

– size : 15-20 µm
– nucleus : round , N\C: 7:1 , 4:1 , reddish purple with delicate chromatin and nucleoli (2-3 )
– cytoplasm : pale to deep blue (basophilic ) with no granules seen by light microscopic .
© 2026 Medical Laboratories. All rights reserved. Site Admin · ·
Powered by WordPress · Powered by Medical Labs